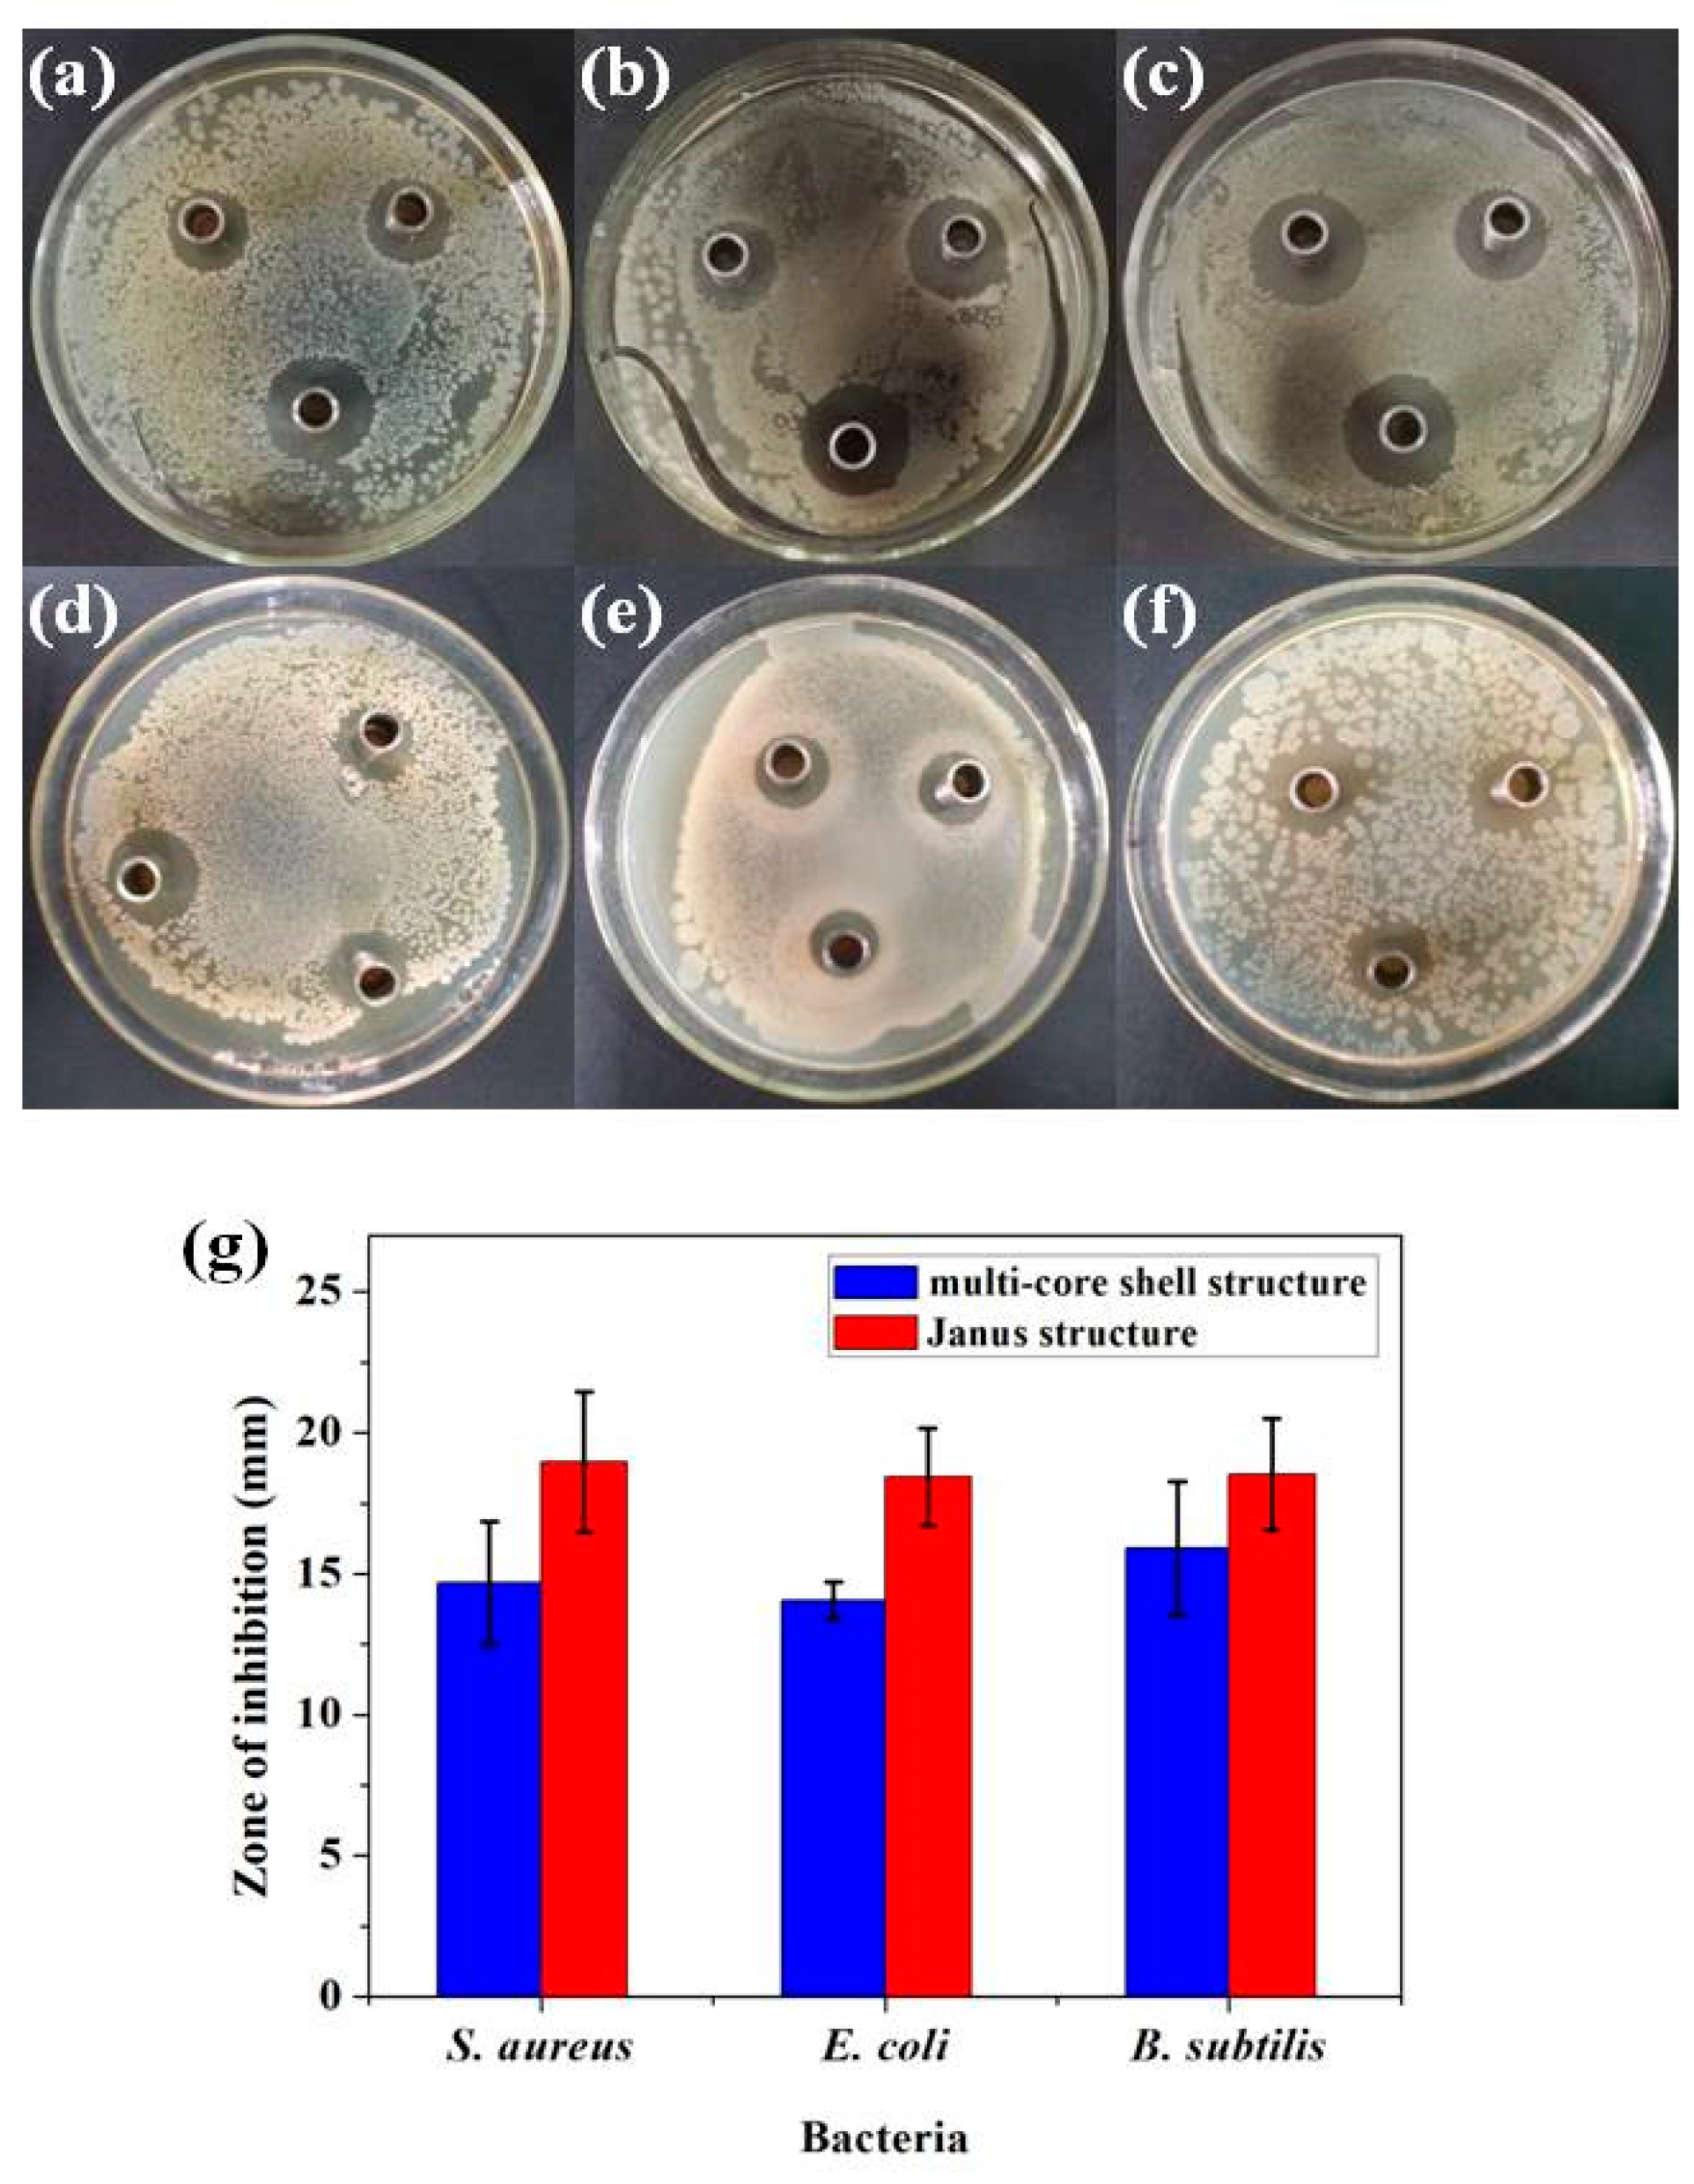
Materials 11 01787 g007

Synthesis and Comparative Biological Properties of Ag-PEG Nanoparticles with Tunable Morphologies from Janus to Multi-Core Shell Structure
Abstract
:1. Introduction
2. Materials and Methods
2.1. Materials
2.2. Measurement
2.3. Synthesis of Thiol-Functionalized Polyethylene Glycol (SH-PEA)
2.4. Synthesis of Ag-PEG Nanoparticles
2.5. Antibacterial Properties of Ag-PEG Nanoparticles
2.6. Cytotoxicity
3. Results and Discussion
3.1. Characterization of the SH-PEA
3.2. Synthesis of Ag-PEG Nanoparticles
3.3. Antibacterial Activity
3.4. Cytotoxicity
4. Conclusions
Author Contributions
Funding
Acknowledgments
Conflicts of Interest
References
- Marambio-Jones, C.; Hoek, E. A review of the antibacterial effects of silver nanomaterials and potential implications for human health and the environment. J. Nanopart. Res. 2010, 12, 1531–1551. [Google Scholar] [CrossRef]
- Arvizo, R.R.; Bhattacharyya, S.; Kudgus, R.A.; Giri, K.; Bhattacharya, R.; Mukherjee, P. Intrinsic therapeutic applications of noble metal nanoparticles: Past, present and future. Chem. Soc. Rev. 2012, 41, 2943–2970. [Google Scholar] [CrossRef] [PubMed]
- Xia, X.; Zeng, J.; McDearmon, B.; Zheng, Y.; Li, Q.; Xia, Y. Silver nanocrystals with concave surfaces and their optical and surface-enhanced raman scattering properties. Angew. Chem. Int. Ed. 2011, 50, 12542–12546. [Google Scholar] [CrossRef] [PubMed]
- Yang, L.; Chen, Y.; Li, H.; Luo, L.; Zhao, Y.; Zhang, H.; Tian, Y. Application of silver nanoparticles decorated with β-cyclodextrin in determination of 6-mercaptopurine by surface-enhanced Raman spectroscopy. Anal. Methods 2015, 7, 6520–6527. [Google Scholar] [CrossRef]
- Yang, K.H.; Chang, C.M. Using a photochemical method and chitosan to prepare surface-enhanced Raman scattering–active silver nanoparticles. Anal. Chim. Acta 2012, 729, 1–6. [Google Scholar] [CrossRef] [PubMed]
- Rycenga, M.; Cobley, C.M.; Zeng, J.; Li, W.; Moran, C.H.; Zhang, Q.; Qin, D.; Xia, Y. Controlling the synthesis and assembly of silver nanostructures for plasmonic applications. Chem. Rev. 2011, 111, 3669–3712. [Google Scholar] [CrossRef] [PubMed]
- Devi, L.B.; Mandal, A.B. Self-assembly of Ag nanoparticles using hydroxypropyl cyclodextrin: Synthesis, characterisation and application for the catalytic reduction of p-nitrophenol. RSC Adv. 2013, 3, 5238–5253. [Google Scholar] [CrossRef]
- Cai, Y.K.; Gao, K.L.; Li, G.C.; Deng, Z.J.; Han, G.Z. Facile controlled synthesis of silver particles with high catalytic activity. Colloid Surf. A 2015, 481, 407–412. [Google Scholar] [CrossRef]
- Li, P.; Li, S.; Wang, Y.; Zhang, Y.; Han, G.Z. Green synthesis of β-CD-functionalized monodispersed silver nanoparticles with ehanced catalytic activity. Colloid Surf. A 2017, 520, 26–31. [Google Scholar] [CrossRef]
- Xue, C.; Mirkin, C.A. pH- switchable silver nanoprism growth pathways. Angew. Chem. Int. Ed. 2007, 46, 2082–2084. [Google Scholar] [CrossRef]
- Sun, Y.; Xia, Y. Shape-controlled synthesis of gold and silver nanoparticles. Science 2002, 298, 2176–2179. [Google Scholar] [CrossRef] [PubMed]
- Ghosh, S.K.; Kundu, S.; Mandal, M.; Nath, S.; Pal, T. Studies on the evolution of silver nanoparticles in micelle by UV-photoactivation. J. Nanopart. Res. 2003, 5, 577–587. [Google Scholar] [CrossRef]
- Sintubin, L.; Verstraete, W.; Boon, N. Biologically produced nanosilver: Current state and future perspectives. Biotechnol. Bioeng. 2012, 109, 2422–2436. [Google Scholar] [CrossRef] [PubMed]
- Kim, D.; Jeong, S.; Moon, J. Synthesis of silver nanoparticles using the polyol process and the influence of precursor injection. Nanotechnology 2006, 17, 4019–4024. [Google Scholar] [CrossRef] [PubMed]
- Huang, L.; Zhai, M.L.; Long, D.W.; Peng, J.; Xu, L.; Wu, G.Z.; Li, J.Q.; Wei, G.S. UV-induced synthesis, characterization and formation mechanism of silver nanoparticles in alkalic carboxymethylated chitosan solution. J. Nanopart. Res. 2008, 10, 1193–1202. [Google Scholar] [CrossRef]
- Maccuspie, R.I. Colloidal stability of silver nanoparticles in biologically relevant conditions. J. Nanopart. Res. 2011, 13, 2893–2908. [Google Scholar] [CrossRef]
- Prathna, T.C.; Chandrasekaran, N.; Mukherjee, A. Studies on aggregation behaviour of silver nanoparticles in aqueous matrices: Effect of surface functionalization and matrix composition. Colloid Surf. A 2011, 390, 216–224. [Google Scholar] [CrossRef]
- Tejamaya, M.; Römer, I.; Merrifield, R.C.; Lead, J.R. Stability of citrate, PVP, and PEG coated silver nanoparticles in ecotoxicology media. Environ. Sci. Technol. 2012, 46, 7011–7017. [Google Scholar] [CrossRef] [PubMed]
- Mallick, K.; Witcomb, M.J.; Scurrell, M.S. Polymer stabilized silver nanoparticles: A photochemical synthesis route. J. Mater. Sci. 2004, 39, 4459–4463. [Google Scholar] [CrossRef]
- Krklješ, A.; Nedeljković, J.M.; Kačarević-Popović, Z.M. Fabrication of Ag-PVA hydrogel nanocomposite by γ-irradiation. Polym. Bull. 2007, 58, 271–279. [Google Scholar] [CrossRef]
- Batista, C.C.S.; Albuquerque, L.J.C.; Araujo, I.D.; Albuquerque, B.L.; Silva, F.D.D.; Giacomelli, F.C. Facile synthesis of 1.3 nm monodispersed Ag nanoclusters in an aqueous solution and their antibacterial activities for E. coli. RSC Adv. 2018, 8, 10873–10882. [Google Scholar] [CrossRef]
- Wu, W.; Zhou, T.; Berliner, A.; Banerjee, P.; Zhou, S. Smart core− shell hybrid nanogels with Ag nanoparticle core for cancer cell imaging and gel shell for pH-regulated drug delivery. Chem. Mater. 2010, 22, 1966–1976. [Google Scholar] [CrossRef]
- Hu, J.; Zhou, S.; Sun, Y.; Fang, X.; Wu, L. Fabrication, properties and applications of Janus particles. Chem. Soc. Rev. 2012, 41, 4356–4378. [Google Scholar] [CrossRef] [PubMed]
- Xu, C.J.; Wang, B.D.; Sun, S.H. Dumbbell-like Au−Fe3O4 nanoparticles for target-specific platin delivery. J. Am. Chem. Soc. 2009, 131, 4216–4217. [Google Scholar] [CrossRef] [PubMed]
- Wang, F.; Pauletti, G.M.; Wang, J.T.; Zhang, J.M.; Ewing, R.C.; Wang, Y.L.; Shi, D.L. Dual surface-functionalized janus nanocomposites of polystyrene/Fe3O4@ SiO2 for simultaneous tumor cell targeting and stimulus-induced drug release. Adv. Mater. 2013, 25, 3485–3489. [Google Scholar] [CrossRef] [PubMed]
- Tran, L.T.C.; Lesieur, S.; Faivre, V. Janus nanoparticles: Materials preparation and recent advances in drug delivery. Expert Opin. Drug Deliv. 2014, 11, 1061–1074. [Google Scholar] [CrossRef] [PubMed]
- Chen, L.; Deming, C.P.; Peng, Y.; Hu, P.; Stofan, J.; Chen, S. Gold core@ silver semishell Janus nanoparticles prepared by interfacial etching. Nanoscale 2016, 8, 14565–14572. [Google Scholar] [CrossRef] [PubMed]
- Song, Y.; Liu, K.; Chen, S. AgAu bimetallic Janus nanoparticles and their electrocatalytic activity for oxygen reduction in alkaline media. Langmuir 2012, 28, 17143–17152. [Google Scholar] [CrossRef] [PubMed]
- Wang, Z.; Chang, Z.; Lu, M.; Shao, D.; Yue, J.; Yang, D.; Li, M.; Dong, W.F. Janus silver/silica nanoplatforms for light-activated liver cancer chemo/photothermal therapy. ACS Appl. Mater. interfaces 2017, 9, 494–496. [Google Scholar] [CrossRef] [PubMed]
- Sun, Y.; Chen, M.; Wang, Z.; Wu, L. Facile synthesis of asymmetric Ag–organosilica hybrid nanoparticles with tunable morphologies and optical properties. Chem. Commun. 2014, 50, 5767–5770. [Google Scholar] [CrossRef] [PubMed]
- Zha, Z.; Teng, W.; Markle, V.; Dai, Z.; Wu, X. Fabrication of gelatin nanofibrous scaffolds using ethanol/phosphate buffer saline as a benign solvent. Biopolymers 2012, 97, 1026–1036. [Google Scholar] [CrossRef] [PubMed]
- Wang, Z.; Zheng, L.; Li, C.; Wu, S.; Xiao, Y. Preparation and antimicrobial activity of sulfopropyl chitosan in an ionic liquid aqueous solution. J. Appl. Polym. Sci. 2017, 134, 44989. [Google Scholar] [CrossRef]
- Ayala-Núñez, N.V.; Villegas, H.H.L.; Turrent, L.C.I.; Padila, C.R. Silver nanoparticles toxicity and bactericidal effect against methicillin-resistant Staphylococcus aureus: Nanoscale does matter. Nanobiotechnol 2009, 5, 2–9. [Google Scholar] [CrossRef]
- Vukomanović, M.; Pepnik, U.; Zavašnik-Bergant, T.; Kostanjšek, R.; Škapin, S.D.; Suvorov, D. Is nano-silver safe within bioactive hydroxyapatite composites? Acs Biomater. Sci. Eng. 2015, 1, 935–946. [Google Scholar] [CrossRef]
- Wen, Y.; Jiang, X.; Yin, G.; Yin, J. Multi-responsive amphiphilic gold nanoparticles (AuNPs) protected by poly (ether amine)(PEA). Chem. Commun. 2009, 43, 6595–6597. [Google Scholar] [CrossRef] [PubMed]
- Peng, Y.K.; Liu, C.L.; Chen, H.C.; Chou, S.W.; Tseng, W.H.; Tseng, Y.J.; Kang, C.C.; Hsiao, J.K.; Chou, P.T. Antiferromagnetic iron nanocolloids: A new generation in vivo T 1 MRI contrast agent. J. Am. Chem. Soc. 2013, 135, 18621–18628. [Google Scholar] [CrossRef] [PubMed]
- Chang, E.; Thekkek, N.; Yu, W.W.; Colvin, V.L.; Drezek, R. Evaluation of quantum dot cytotoxicity based on intracellular uptake. Small 2006, 2, 1412–1417. [Google Scholar] [CrossRef] [PubMed]
- Tsuchida, E.; Sou, K.; Nakagawa, A.; Sakai, H.; Komastsu, T.; Kobayashi, K. Artificial oxygen carriers, hemoglobin vesicles and albumin− hemes, based on bioconjugate chemistry. Bioconjugate Chem. 2009, 20, 1419–1440. [Google Scholar] [CrossRef] [PubMed]
- Scaravelli, R.C.B.; Dazzi, R.L.; Giacomelli, F.C.; Machado, G.; Giacomelli, C.; Schmidt, V. Direct synthesis of coated gold nanoparticles mediated by polymers with amino groups. J. Colloid Interf. Sci. 2013, 397, 114–121. [Google Scholar] [CrossRef] [PubMed]
- Batista, C.; Albuquerque, L.; Ribeiro, C.; de Castro, C.; Miranda, E.; Nantes, I.; Albuquerque, B.; Cardoso, M.; Giacomelli, F. Nano-Sized Silver Colloids Produced and Stabilized by Amino-Functionalized Polymers: Polymer Structure-Nanoparticle Features and Polymer Structure-Growth Kinetics Relationships. J. Braz. Chem. Soc. 2017, 28, 1608–1618. [Google Scholar] [CrossRef]
- Langille, M.R.; Personick, L.M.; Mirkin, C.A. Plasmon-mediated syntheses of metallic nanostructures. Angew. Chem. Int. Ed. 2013, 52, 13910–13940. [Google Scholar] [CrossRef] [PubMed]
- Ye, S.; Song, J.; Tian, Y.L.; Chen, L.C.; Wang, D.; Niu, H.B.; Qu, J.L. Photochemically grown silver nanodecahedra with precise tuning of plasmonic resonance. Nanoscale 2015, 7, 12706–12712. [Google Scholar] [CrossRef] [PubMed]
- Yang, L.C.; Lai, Y.S.; Tsai, C.M.; Kong, Y.T.; Lee, C.I.; Huang, C.L. Transformation from silver nanoprisms to nanodecahedra in a temperature-controlled photomediated synthesis. J. Phys. Chem. C 2012, 116, 24268–24273. [Google Scholar]
- Romanovskaya, G.I.; Koroleva, M.V.; Zuev, B.K. Photochemical Synthesis of Anisotropic Silver Nanoparticles in Aqueous Solutions in the Presence of Sodium Citrate. Dokl. Chem. 2018, 480, 96–98. [Google Scholar] [CrossRef]
- Johnston, H.J.; Hutchison, G.; Christensen, F.M.; Peters, S.; Hankin, S.; Stone, V. A review of the in vivo and in vitro toxicity of silver and gold particulates: Particle attributes and biological mechanisms responsible for the observed toxicity. Crit. Rev. Toxicol. 2010, 40, 328–346. [Google Scholar] [CrossRef] [PubMed]
- Hunt, P.R.; Keltner, Z.; Guo, X.; Oldenburg, S.J.; Bushana, P.; Olejnik, N.; Sprando, R.L. Bioactivity of nanosilver in Caenorhabditis elegans: Effects of size, coat, and shape. Toxicol. Rep. 2014, 1, 923–944. [Google Scholar] [CrossRef] [PubMed]
- Ahmed, K.B.R.; Nagy, A.M.; Brown, R.P.; Zhang, Q.; Malghan, S.G.; Goering, P.L. Silver nanoparticles: Significance of physicochemical properties and assay interference on the interpretation of in vitro cytotoxicity studies. Toxicol. In Vitro 2017, 38, 179–192. [Google Scholar] [CrossRef] [PubMed]

| Bacterial Strain | Janus Structure (μg mL−1) | Multi-Core Shell Structure (μg mL−1) | ||||
|---|---|---|---|---|---|---|
| MIC | MBC | MBC/MIC Ratio | MIC | MBC | MBC/MIC Ratio | |
| S. aureus | 64 | 500 | 8 | 16 | 64 | 4 |
| E. coli | 32 | 500 | 16 | 16 | 32 | 2 |
| B. subtilis | 64 | 250 | 4 | 16 | 32 | 2 |
© 2018 by the authors. Licensee MDPI, Basel, Switzerland. This article is an open access article distributed under the terms and conditions of the Creative Commons Attribution (CC BY) license (http://creativecommons.org/licenses/by/4.0/).
Share and Cite
Xu, M.; Liu, J.; Xu, X.; Liu, S.; Peterka, F.; Ren, Y.; Zhu, X. Synthesis and Comparative Biological Properties of Ag-PEG Nanoparticles with Tunable Morphologies from Janus to Multi-Core Shell Structure. Materials 2018, 11, 1787. https://doi.org/10.3390/ma11101787
Xu M, Liu J, Xu X, Liu S, Peterka F, Ren Y, Zhu X. Synthesis and Comparative Biological Properties of Ag-PEG Nanoparticles with Tunable Morphologies from Janus to Multi-Core Shell Structure. Materials. 2018; 11(10):1787. https://doi.org/10.3390/ma11101787
Chicago/Turabian StyleXu, Mengda, Jie Liu, Xiankui Xu, Shanhu Liu, František Peterka, Yanrong Ren, and Xianfeng Zhu. 2018. "Synthesis and Comparative Biological Properties of Ag-PEG Nanoparticles with Tunable Morphologies from Janus to Multi-Core Shell Structure" Materials 11, no. 10: 1787. https://doi.org/10.3390/ma11101787
APA StyleXu, M., Liu, J., Xu, X., Liu, S., Peterka, F., Ren, Y., & Zhu, X. (2018). Synthesis and Comparative Biological Properties of Ag-PEG Nanoparticles with Tunable Morphologies from Janus to Multi-Core Shell Structure. Materials, 11(10), 1787. https://doi.org/10.3390/ma11101787

